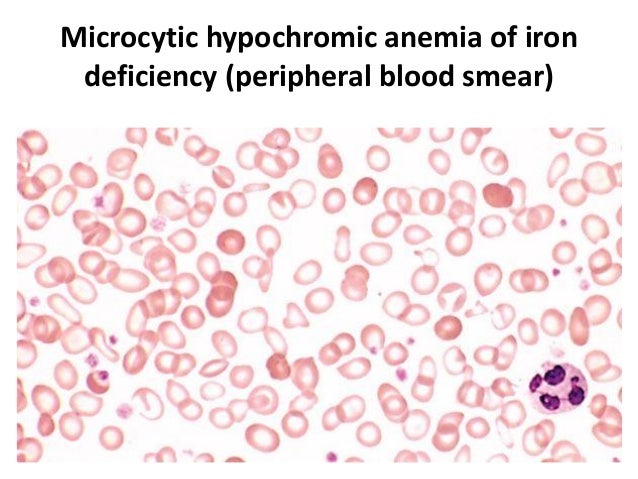

Sickle Cell Disease: This inherited disorder impacts the shape of RBCs.This cause also enlarges the kidneys and loses their primary function of purifying blood. Polycystic Kidney Disease: Patients suffering from polycystic kidney disease get cysts that grow in their kidneys.The following are the most crucial chronic causes of having RBC in urine: With the protein myoglobin being dumped into the blood, some RBCs also flow into the urine, departing the colour.Ĭertain long-term diseases or medical conditions can also increase RBC counts during urine tests. Rhabdomyolysis: Patients suffering from rhabdomyolysis often witness reddish-brown urine.People who work out for longer hours without being properly hydrated are likely to have high RBC in urine.

The duration of exercising also influences the number of RBCs spotted in urine.
The symptoms for these causes get better as the treatment progresses. These are the causes that arise from a temporary health condition that affects the body only for a short period of time. Below are some of the most common causes of witnessing high RBC count in urine: Acute Causes While sometimes it may be a symptom of irritation in the urinary tract, there can be cases where it indicates a serious medical condition. Having high RBC in urine can be due to acute or chronic diseases.
